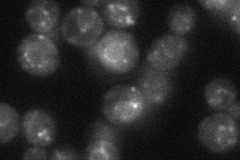
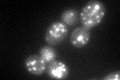

View description
Putative prenyltransferase, required for cell viability; proposed to be involved in protein trafficking because tet-repressible mutant shows accumulation of hypoglycosylated forms of CPY
Localization:
Intensity:
Fold change:
Significance:
-
C’ GFP library in SD

punctate,ER48.13 -
N' NOP1pr-GFP in SD

punctate106.112 -
N' TEF2pr-mCherry in SD

punctate149.41 -
N' NATIVEpr-GFP in SD
ER,punctate44.3651 -
N' TEF2pr-VC and Cyto-VN in SD

punctate48.4679 -
C’ GFP library in SD+DTT
punctate,ER65.921.36Yes -
C’ GFP library in SD+H2O2

punctate,ER40.750.84No -
C’ GFP library in Starvation Media

punctate,ER73.091.51Yes -
C’ GFP library on the background of Pup2-DaMP

N/A -
C’ GFP library on the background of CCT mutant

N/A0N/AYes
